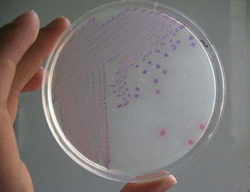

微生物测试评估(Microbiological Test)的微生物指标主要包括:细菌总数、霉菌和酵母、绿脓杆菌、金黄色葡萄球菌、大肠杆菌、沙门氏菌、白色念珠菌、梭状芽孢杆菌、肠杆菌属及革兰氏阴性菌和胆汁耐受革兰氏阴性菌。
微生物测试所依据的法规/标准包括:
●欧洲药典(EP 2.6.12 & 2.6.13);
●英国药典(BP Appx. XVI B);
●美国药典(USP61&62);
●欧盟化妆用品及香料协会指引(Cosmetics Europe);
●化妆品及香料协会(TFA)。
具体问题请咨询IDOTEK艾多检测
全国统一服务热线:400-6177-880
Email:service@idotek.com